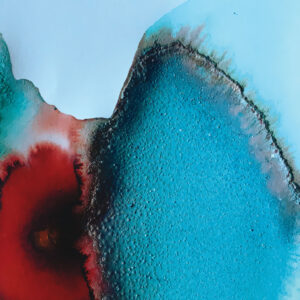
INKQ Issue #11 feature

All items

041020151159
from £100.00 Populus x canadensisPrintsView itemSelect options This product has multiple variants. The options may be chosen on the product page 
041120151155
from £100.00 Populus x canadensisPrintsView itemSelect options This product has multiple variants. The options may be chosen on the product page 
041120151204
from £100.00 Vitis viniferaPrintsView itemSelect options This product has multiple variants. The options may be chosen on the product page 
041120151206
from £100.00 Vitis viniferaPrintsView itemSelect options This product has multiple variants. The options may be chosen on the product page 
041120151210
from £100.00 Cercis siliquastrumPrintsView itemSelect options This product has multiple variants. The options may be chosen on the product page 
071120151031
from £100.00 Catalpa bignonioidesPrintsView itemSelect options This product has multiple variants. The options may be chosen on the product page 
100820151542
from £100.00 Catalpa bignonioidesPrintsView itemSelect options This product has multiple variants. The options may be chosen on the product page 
120820141314
from £100.00 Ricinus communisPrintsView itemSelect options This product has multiple variants. The options may be chosen on the product page 
140120160943
from £100.00 Acer pseudoplatanusPrintsView itemSelect options This product has multiple variants. The options may be chosen on the product page 
150620151536
from £100.00 Cynara cardunculus var. scolymusPrintsView itemSelect options This product has multiple variants. The options may be chosen on the product page 
181120141339
from £100.00 Cynara cardunculus var. scolymusPrintsView itemSelect options This product has multiple variants. The options may be chosen on the product page 
200720140950
from £100.00 Catalpa bignonioidesPrintsView itemSelect options This product has multiple variants. The options may be chosen on the product page 
201020151203
from £100.00 Populus x canadensisPrintsView itemSelect options This product has multiple variants. The options may be chosen on the product page 
250220162005
from £60.00 Ginkgo bilobaPrintsView itemSelect options This product has multiple variants. The options may be chosen on the product page 
250220162008
from £60.00 Ginkgo bilobaPrintsView itemSelect options This product has multiple variants. The options may be chosen on the product page 
300620161144
from £100.00 Quercus roburPrintsView itemSelect options This product has multiple variants. The options may be chosen on the product page 
300720150946
from £100.00 Catalpa bignonioidesPrintsView itemSelect options This product has multiple variants. The options may be chosen on the product page 
300920151946
from £100.00 Populus x canadensisPrintsView itemSelect options This product has multiple variants. The options may be chosen on the product page 
A Cage of Discarded Antlers (Love in a Mist)
from £100.00 PrintsView itemSelect options This product has multiple variants. The options may be chosen on the product page 
Blackberry
from £60.00 Rubus ulmifoliusPrintsView itemSelect options This product has multiple variants. The options may be chosen on the product page 
Blaue Blume
£100.00 BooksView itemAdd to cart 
Blaue Blume Greetings Card Pack
£18.00 Greetings cardsView itemAdd to cart 
Blue Flame
from £100.00 PrintsView itemSelect options This product has multiple variants. The options may be chosen on the product page 
Blue Rose
Original ArtView itemRead more 
Cleft
£5,000.00 Original ArtView itemAdd to cart 
Conker Leaf
Original ArtView itemRead more 
Consolida II
£1,400.00 Original ArtView itemAdd to cart 
Cos Lettuce
from £60.00 Lactuca sp.PrintsView itemSelect options This product has multiple variants. The options may be chosen on the product page 
Gentian
£1,200.00 Original ArtView itemAdd to cart 
Giant Pandemic Pansy III
£3,500.00 Original ArtView itemAdd to cart 
Giant Pansy I
from £120.00 PrintsView itemSelect options This product has multiple variants. The options may be chosen on the product page 
Giant Pansy III
from £120.00 PrintsView itemSelect options This product has multiple variants. The options may be chosen on the product page 
Gooseberry
from £60.00 Ribes uva-crispaPrintsView itemSelect options This product has multiple variants. The options may be chosen on the product page 
I don’t want you
£600.00 Original ArtView itemAdd to cart 
INKQ Edition #1
£10.00 INKQView itemRead more 
INKQ Edition #10
£10.00 INKQView itemAdd to cart
INKQ Edition #11
£10.00 INKQView itemAdd to cart 
INKQ Edition #12
£10.00 INKQView itemAdd to cart 
INKQ Edition #2
£10.00 INKQView itemAdd to cart 
INKQ Edition #3
£10.00 INKQView itemRead more 
INKQ Edition #4
£10.00 INKQView itemAdd to cart 
INKQ Edition #5
£10.00 INKQView itemAdd to cart 
INKQ Edition #6
£10.00 INKQView itemAdd to cart 
INKQ Edition #7
£10.00 INKQView itemAdd to cart 
INKQ Edition #8
£10.00 INKQView itemAdd to cart 
INKQ Edition #9
£10.00 INKQView itemAdd to cart 
Instar
£1,600.00 Original ArtView itemAdd to cart 
Lament
Original ArtView itemRead more 
Leafscape
£110.00 BooksView itemRead more 
Leafscape – Redux
£30.00 BooksView itemRead more 
Leafscape Audio
£14.00 SoundView itemAdd to cart 
Leafscape greetings card pack
£18.00 Greetings cardsView itemRead more 
Limited edition Blue Flower square greetings card pack
£12.00 Greetings cardsView itemRead more 
Love in a Mist
Original ArtView itemRead more 
Mar’rallang
Original ArtView itemRead more 
Ophelia
from £60.00 Phalaenopsis sp.PrintsView itemSelect options This product has multiple variants. The options may be chosen on the product page 
Pandemic Pansies I
from £120.00 PrintsView itemSelect options This product has multiple variants. The options may be chosen on the product page 
Pandemic Pansy – Giant I
£3,500.00 Original ArtView itemAdd to cart 
Pansy greetings card pack
£15.00 Greetings cardsView itemAdd to cart 
Pineapple Obi-Wan
from £60.00 Ananas comosusPrintsView itemSelect options This product has multiple variants. The options may be chosen on the product page 
Plaza Leaf
£15,000.00 Original ArtView itemAdd to cart 
Spine
£600.00 Original ArtView itemAdd to cart 
The Green Giant
from £60.00 Coffea arabicaPrintsView itemSelect options This product has multiple variants. The options may be chosen on the product page 
The Kiss: Onslow Gardens
from £100.00 PrintsView itemSelect options This product has multiple variants. The options may be chosen on the product page 
Tipping Point
Original ArtView itemRead more 
Twenty seven degrees
Original ArtView itemRead more 
Twenty seven degrees
from £100.00 PrintsView itemSelect options This product has multiple variants. The options may be chosen on the product page 
Word of Mouth
£36.00 BooksView itemAdd to cart